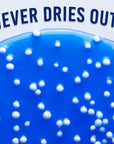

Crazy Aaron’s Crackle’n Kracken Popp’n Thinking Putty®
$14.95
- Blue base with white (foam) beads
- Stretch it, bounce it, pop it, tear it, and sculpt it!
- Never dries out!
- Fun for ages 3+
- Includes 1/5 lb (90 g) of Genuine Crazy Aaron's Thinking Putty
- Made in the USA with the finest materials from around the world
Putty that crackles, pops, and snaps! Crackle’n Kraken’s blue putty includes
soft foam beads that create an extra satisfying auditory sensation. Thinking
Putty helps build hand and finger strength through a tactile play experience
and provides relaxing, yet stimulating interaction. Crazy Aaron's putty is
non-toxic, won't dry out, and won't leave a sticky residue on your fingers.